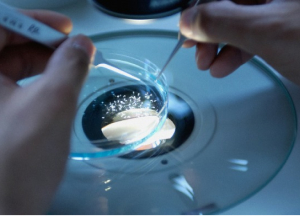

Redefining AI Innovation for Everyone
Welcome to Neovivum, where we deliver cutting-edge research and technology to tackle the world’s toughest challenges head-on

Neovivum: A Paradigm Change Maker
Our vision is to tackle the world’s most pressing challenges with cutting-edge research and technology.
We find solutions by analyzing phenomena with groundbreaking scientific studies and developing enabling technologies.
We support government agencies and large corporations in implementing paradigm change based on scientific discoveries and technological breakthroughs.
OUR SERVICES

Studies
We assemble teams of academic leaders and industry experts to delve into research questions, bridging the gap between theory and practice
Research
Our in-house research efforts drive innovation across diverse fields, pushing boundaries and advancing knowledge

Development
We pioneer cutting-edge technology solutions across industries, offering fresh perspectives to address longstanding challenges

Modeling
Our modeling services simulate real-world scenarios, providing valuable insights to inform decision-making and optimize outcomes
OUR TEAM
RESEARCH DOMAINS
Climate and Biosphere
Climate change affects all industries – climate science helps examine relevant variables.
RESOURCES
GET IN TOUCH
Our Location: Vojvode Putnika 4, 21000 Novi Sad, Serbia








